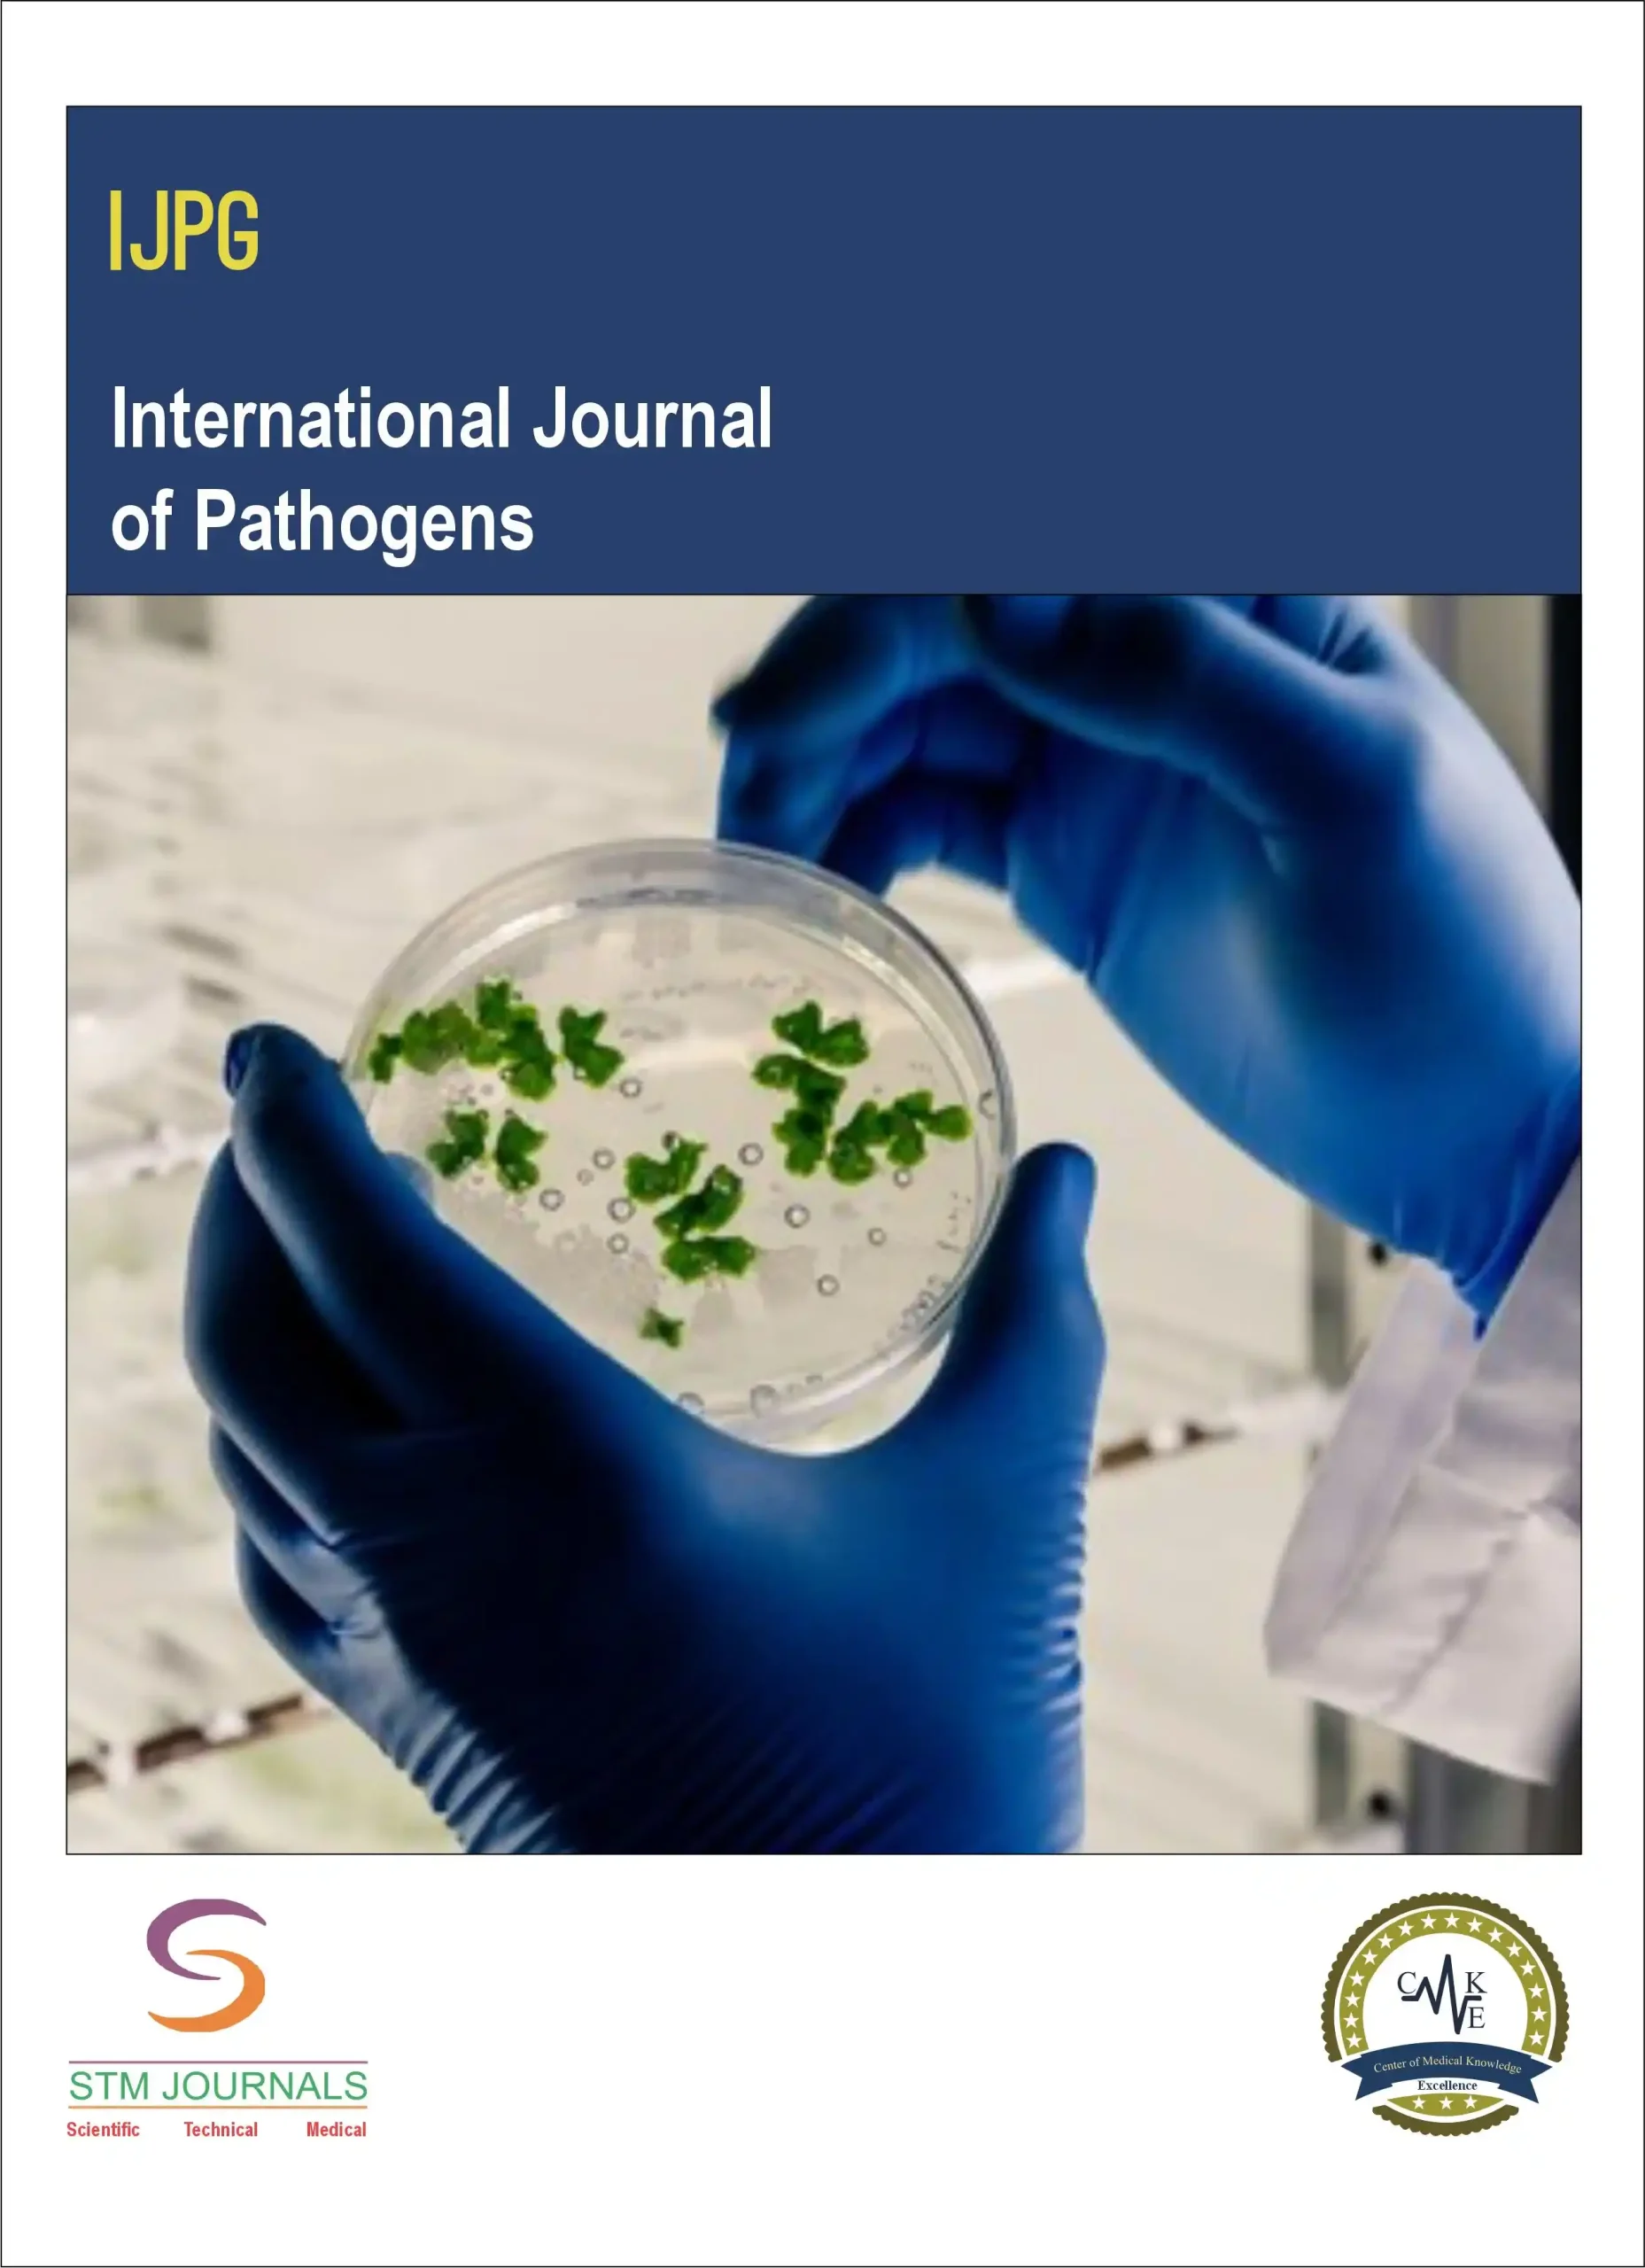
International Journal of Pathogens

International Journal of Pathogens
The International Journal of Pathogens by STM Journals is a trusted peer-reviewed academic journal focusing on the study of pathogens and infectious diseases. This journal serves as a comprehensive resource for researchers, healthcare professionals, and educators seeking the latest advances in pathogen biology, disease mechanisms, and control strategies.
What This Journal Covers: Key Focus Areas
This journal encompasses a comprehensive range of critical topics in pathogen research:
-
Pathogen Biology & Pathogenesis: Investigating microbial structure, genetics, virulence factors, and the molecular mechanisms of host-pathogen interactions.
-
Host Immune Response & Immunology: Research on innate and adaptive immunity to pathogens, immune evasion strategies, and correlates of protection.
-
Diagnostic Microbiology & Molecular Detection: Innovations in culture-independent diagnostics, PCR-based assays, next-generation sequencing, and point-of-care testing for accurate pathogen identification.
-
Epidemiology & Outbreak Investigation: Tracking the transmission dynamics, geographic spread, and evolutionary trends of endemic and emerging pathogens.
-
Antimicrobial Agents & Resistance: Studies on the discovery of new antibiotics, antivirals, and antifungals, alongside the mechanisms and surveillance of antimicrobial resistance (AMR).
Who Should Read the Journal
This publication is an essential resource for:
-
Medical Microbiologists and Pathologists involved in clinical diagnostics and laboratory research.
-
Infectious Disease Specialists and Clinicians seeking to understand pathogen behavior and treatment options.
-
Public Health Researchers and Epidemiologists tracking and managing disease outbreaks.
-
Molecular Biologists and Biotechnologists developing new detection methods and therapeutics.
-
Academic Researchers and Students in microbiology, immunology, and public health.
Why It Matters
Pathogens are a constant and evolving challenge to human health. This journal is critical for:
-
Understanding Emerging Threats: Providing a platform for rapid dissemination of research on new and re-emerging pathogenic threats.
-
Combating Antimicrobial Resistance: Sharing vital research on one of the most pressing global health challenges of our time.
-
Bridging Bench to Bedside: Translating basic discoveries in pathogen biology into new diagnostic, therapeutic, and preventive applications.
-
Enhancing Global Health Security: Contributing to the knowledge base needed for effective disease surveillance, outbreak response, and public health preparedness.
Submission & Peer-Review
Available in both online and print formats:
-
Online Subscription: Access full issues and archives anytime, anywhere through STM Journals’ user-friendly digital platform.
-
Print Subscription: Receive physical copies delivered to your institution or home for ease of reference and study.
Subscription plans and bulk orders are available directly via the STM Journals website or customer support team.
Why Choose STM Journals?
STM Journals is a trusted publisher committed to excellence in scientific communication, offering:
-
Rigorous Peer-Review: Ensuring the validity, significance, and originality of every published work.
-
Global Reach and Indexing: Maximizing the visibility and impact of your research worldwide.
-
Rapid Publication Process: A streamlined workflow to share critical pathogen research findings with the global community without delay.
-
Dedicated Focus: A specialized platform championing comprehensive research on all categories of pathogens.